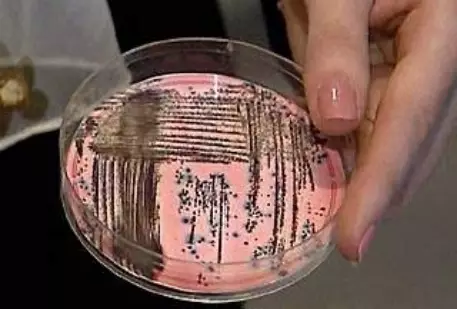

Зараженных сибирской язвой жителей Павлодарской области выписали из больницы, передает "Интерфакс-Казахстан" со ссылкой на МЧС республики. Жители сел Караколь и Ребровка прошли соответствующее лечение. "Все больные выписаны, вновь поступивших нет", - говорится в сообщении ведомства. 119 контактным провели тетрациклиновую терапию. Напомним, в июне этого года сибирской язвой заразились шесть жителей Павлодарской области. Также госпитализировали 16 контактировавших с больными. Причиной вспышки инфекции стало мясо забитого быка. Первый случай заболевания был зафиксирован 19 июня. Двое жителей Аксуского района скончались. Сибирская язва - это острая бактериальная инфекция, которая поражает кожу, лимфатические узлы и внутренние органы человека. Название болезни дал русский врач Андреевский. В 1788 году он описал эпидемию этого заболевания в Западной Сибири. Разносчиками инфекции являются больные домашние животные - коровы, лошади, ослы, овцы, козы, олени, верблюды, свиньи.
Зараженных сибирской язвой жителей Павлодарской области выписали из больницы, передает "Интерфакс-Казахстан" со ссылкой на МЧС республики. Жители сел Караколь и Ребровка прошли соответствующее лечение. "Все больные выписаны, вновь поступивших нет", - говорится в сообщении ведомства. 119 контактным провели тетрациклиновую терапию.
Напомним, в июне этого года сибирской язвой заразились шесть жителей Павлодарской области. Также госпитализировали 16 контактировавших с больными. Причиной вспышки инфекции стало мясо забитого быка. Первый случай заболевания был зафиксирован 19 июня. Двое жителей Аксуского района скончались.
Сибирская язва - это острая бактериальная инфекция, которая поражает кожу, лимфатические узлы и внутренние органы человека. Название болезни дал русский врач Андреевский. В 1788 году он описал эпидемию этого заболевания в Западной Сибири. Разносчиками инфекции являются больные домашние животные - коровы, лошади, ослы, овцы, козы, олени, верблюды, свиньи.


